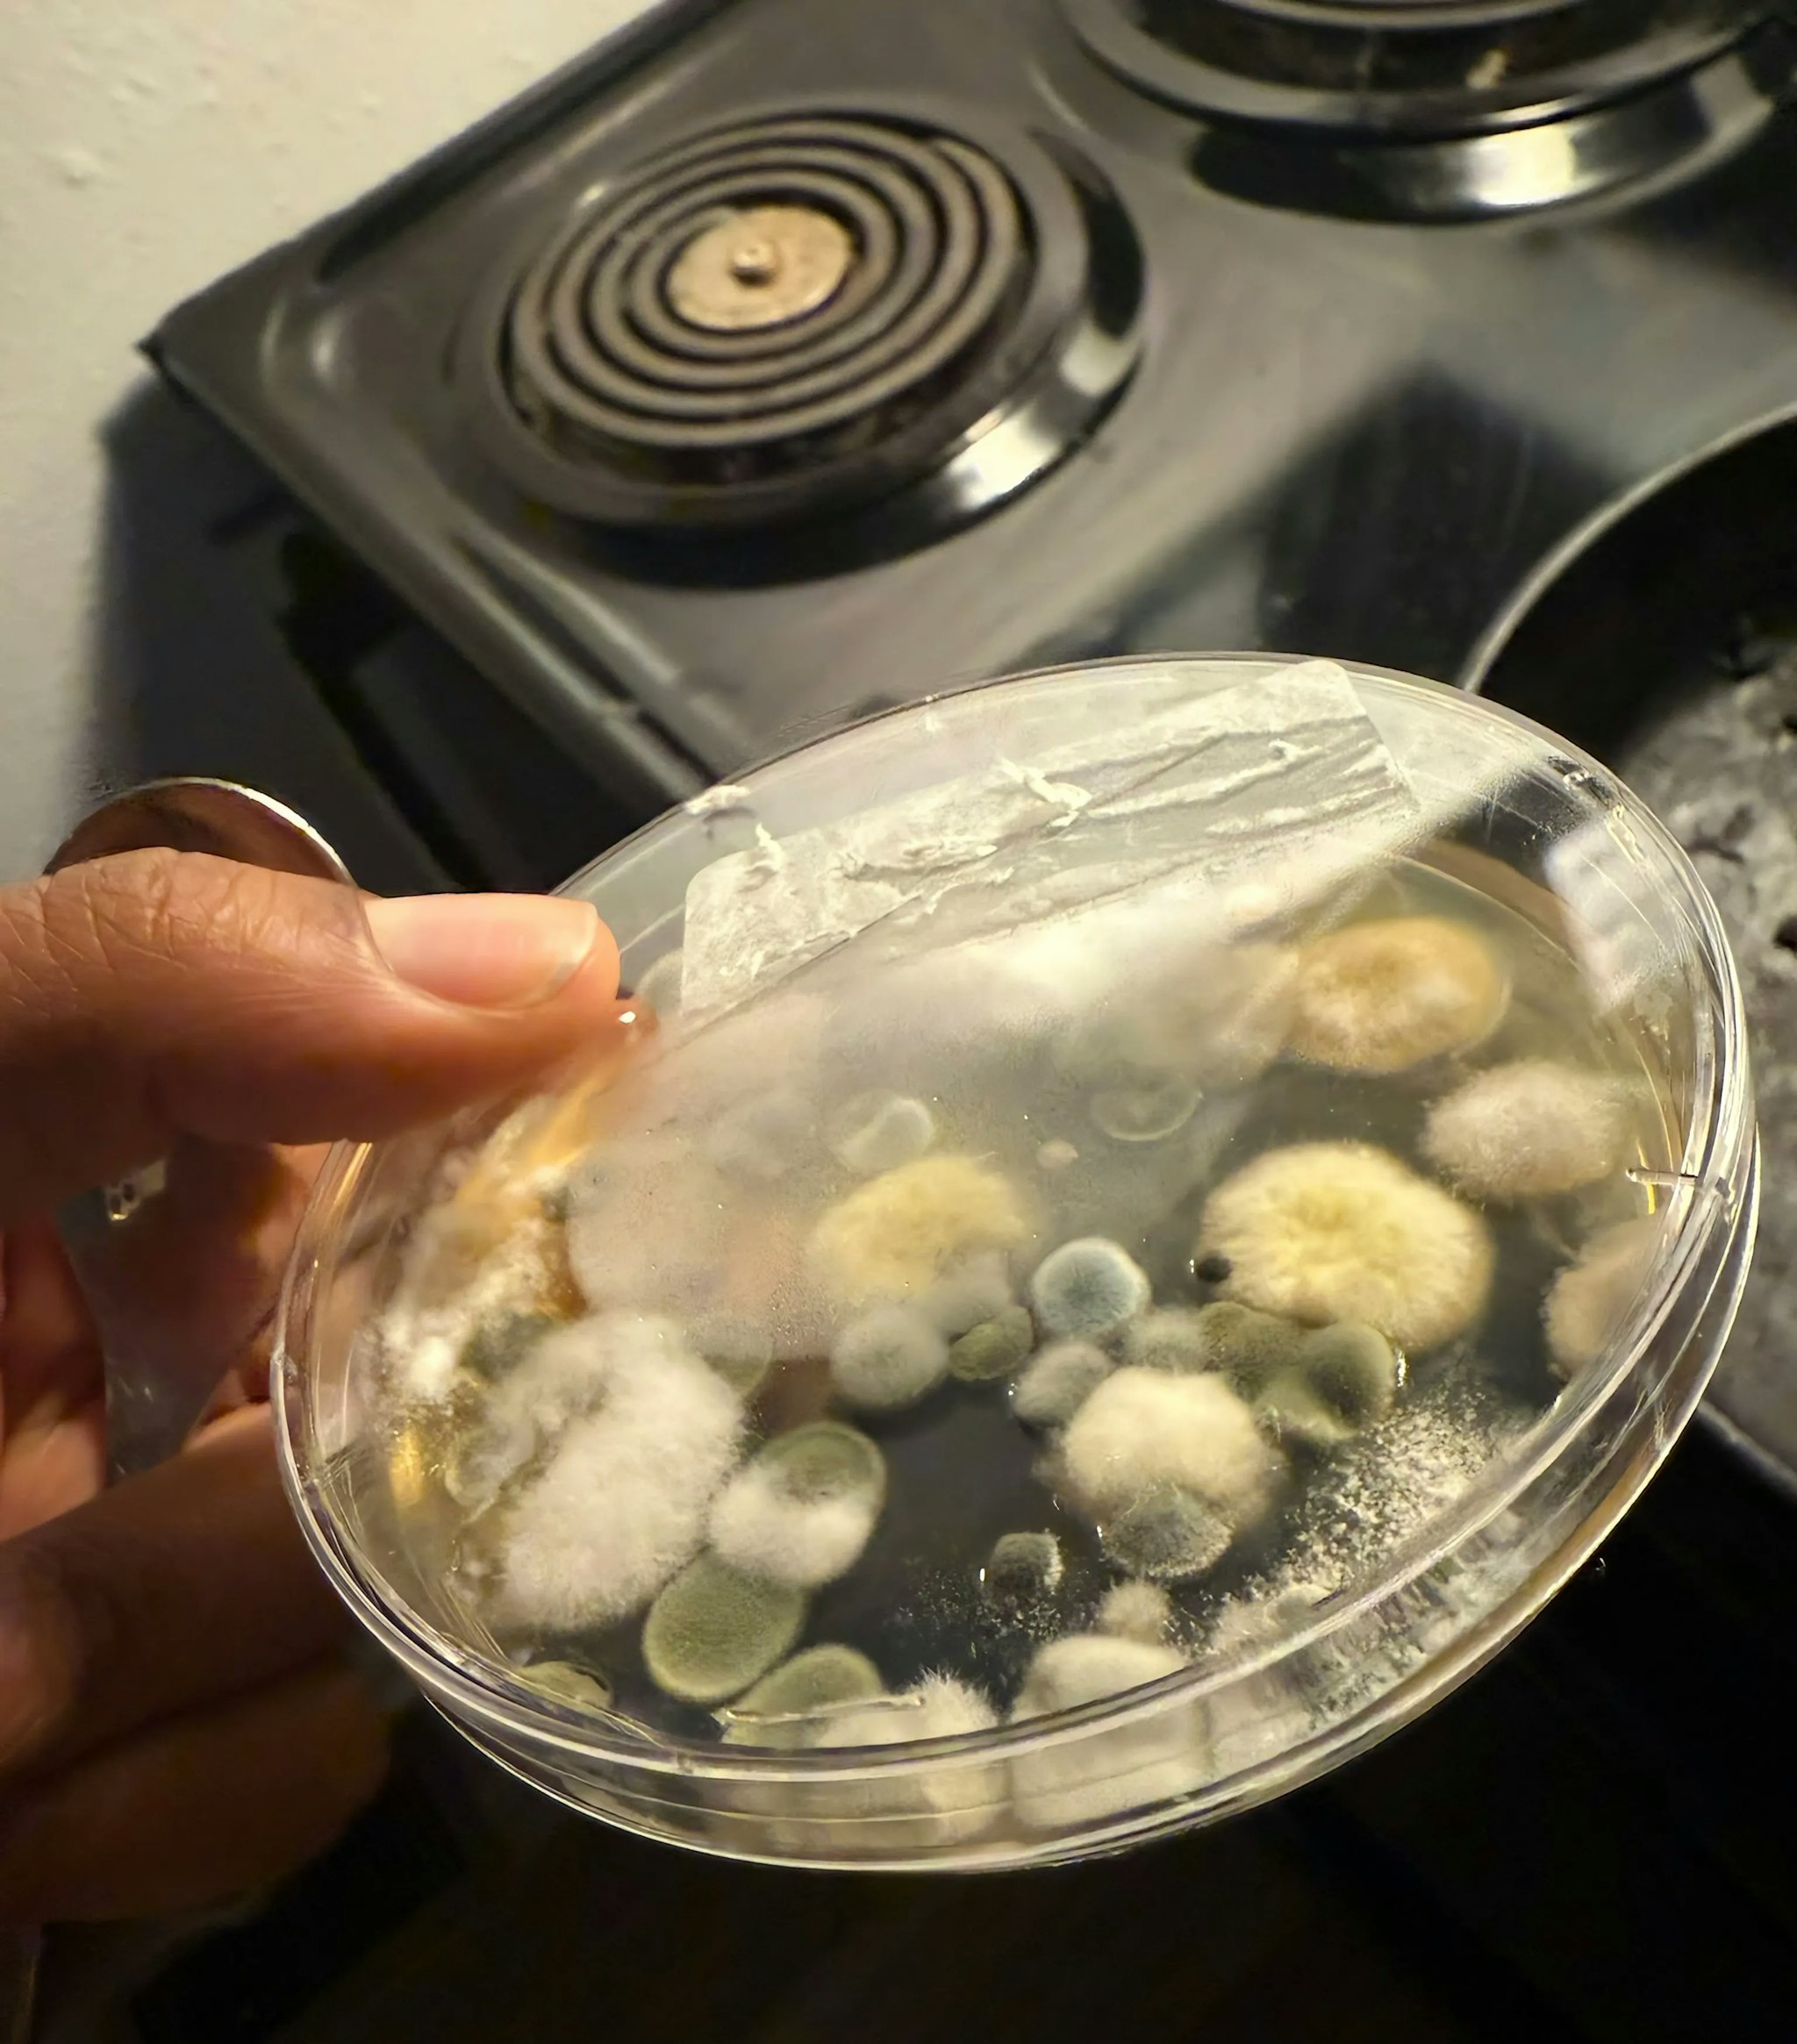
Video component image
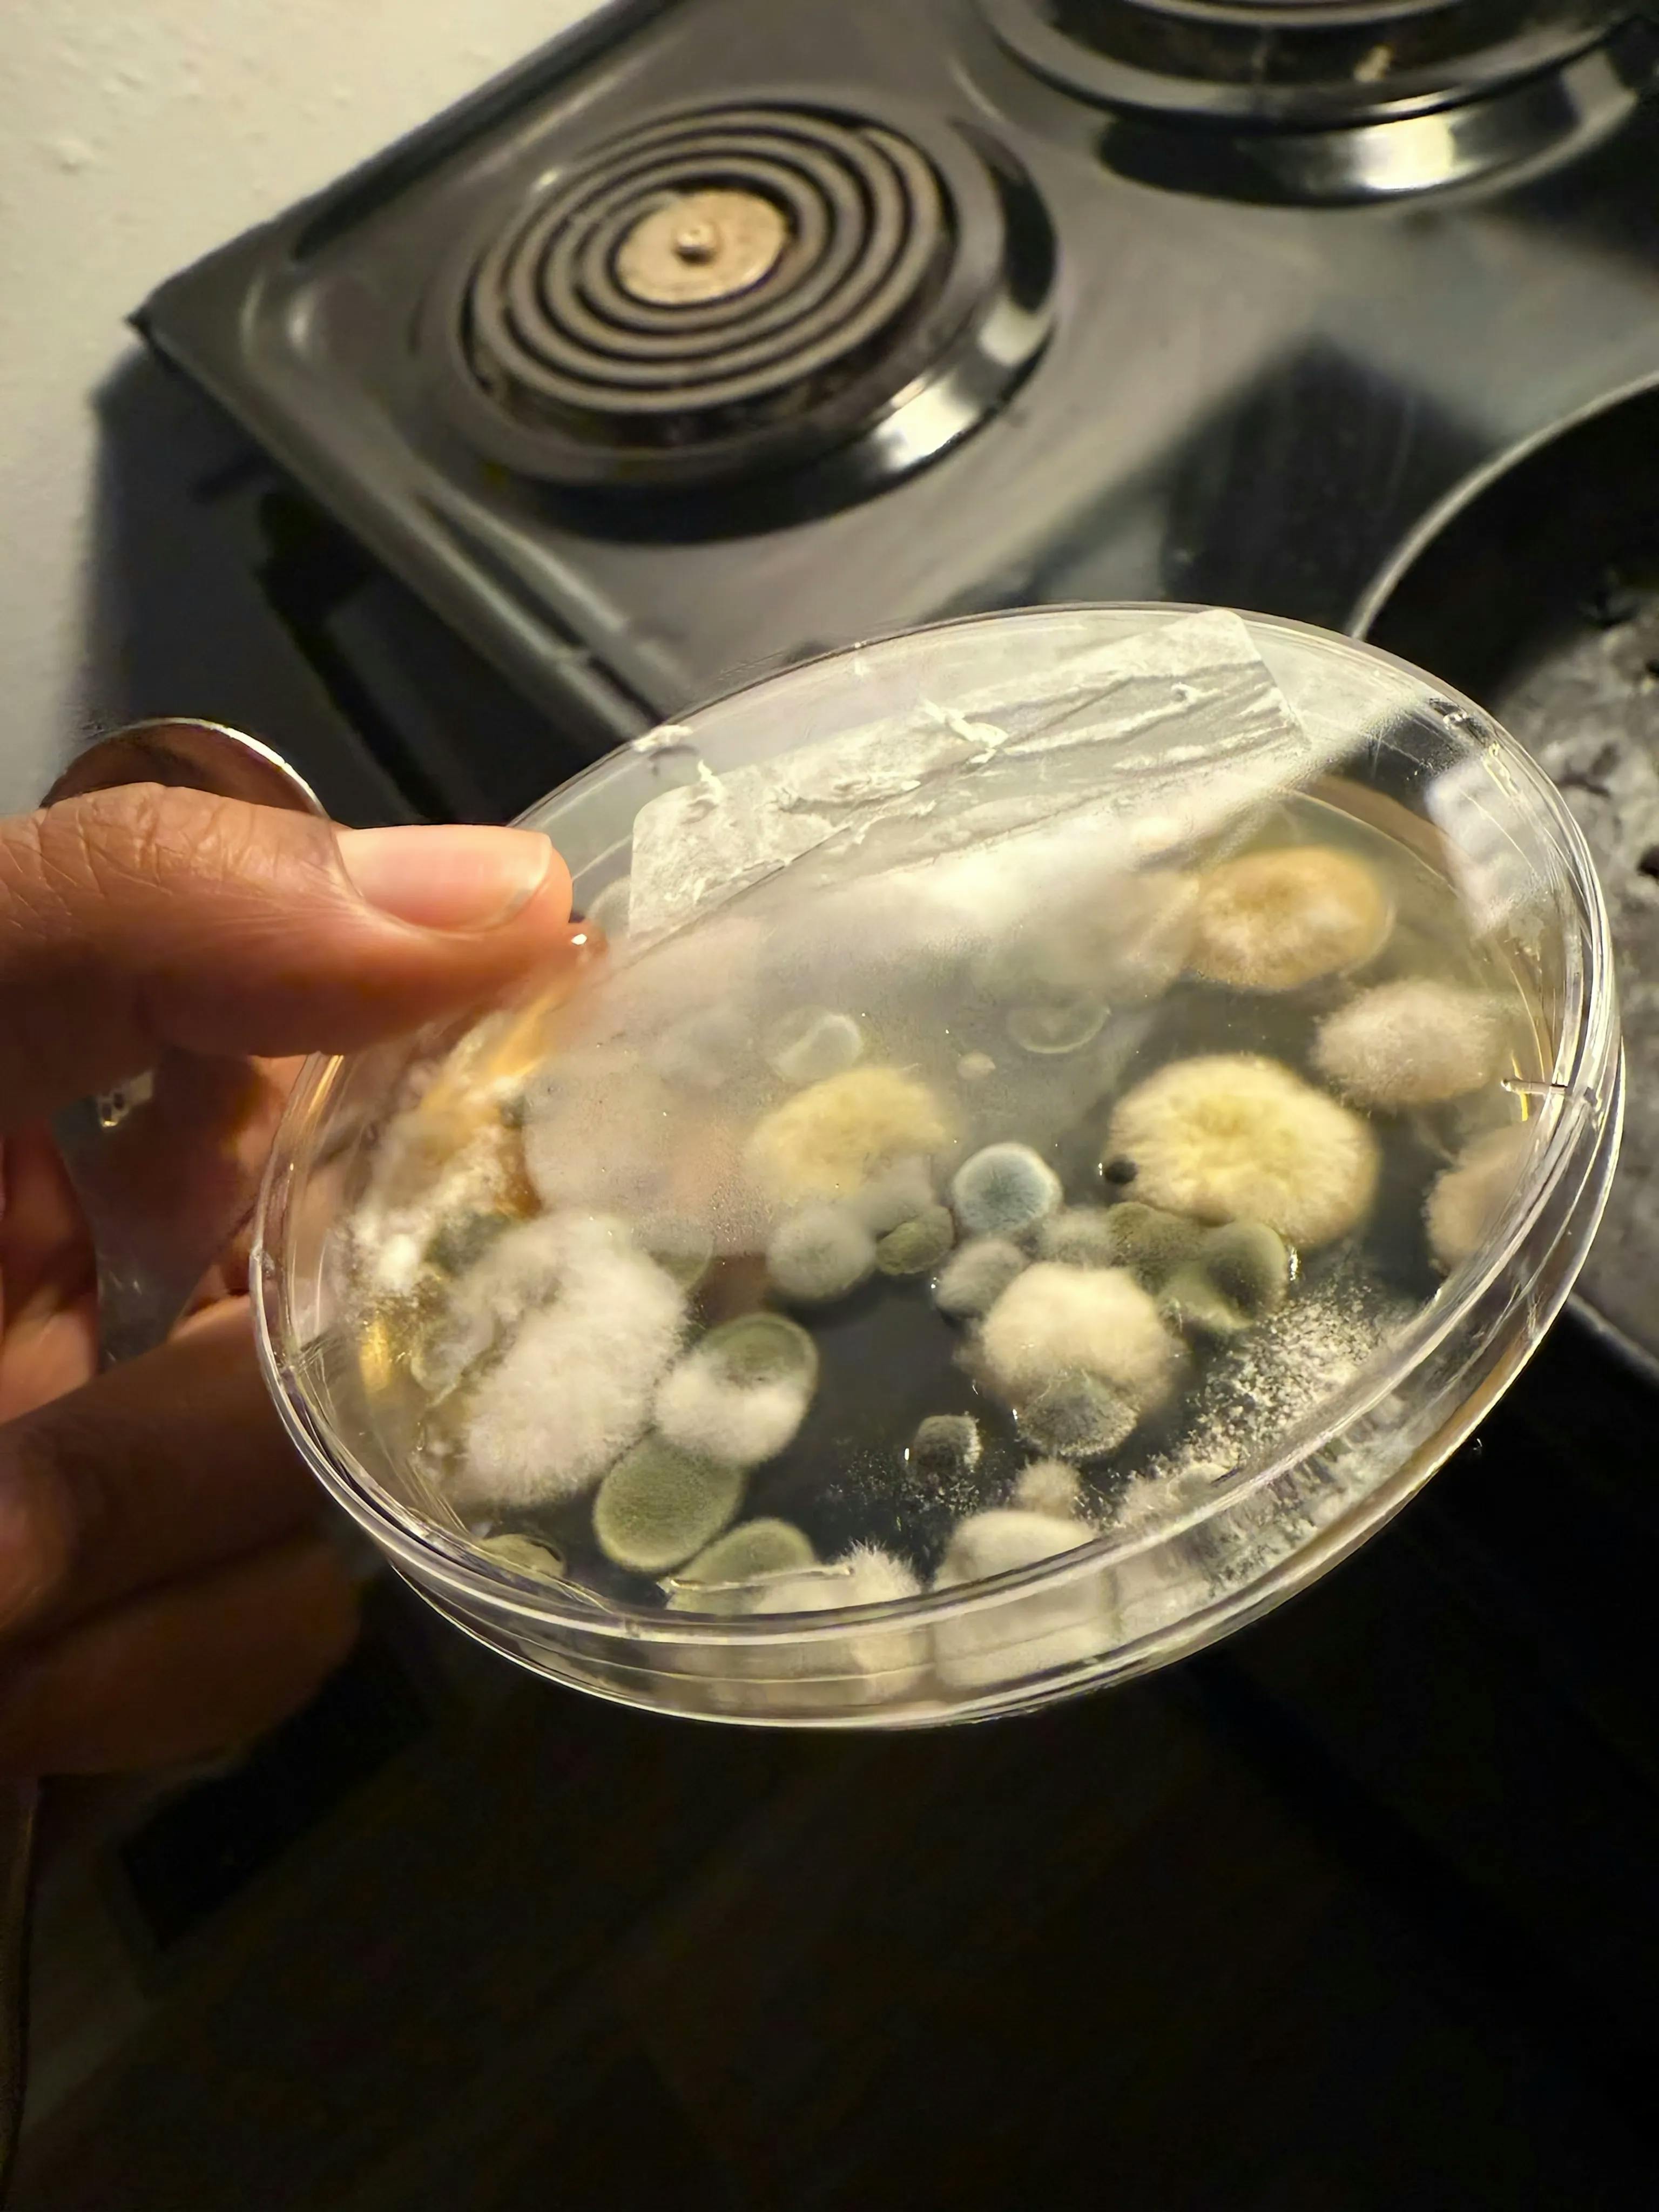
Video component image

Addressing Failures in Housing
Addressing Failures in Housing
Mold and Water Leaks
Slumlords in St. Louis
Special Guest: Luciana
Fundraising with Friends
Fundraising with Friends
Late Night Chat
A 24- hour plan turned into a 7-hour Marathon Fundraiser.
Special Guests: Luis and Rachel
#Healthcare #2022Flood #Seniors #HarveyMilk #Ridesharing #Fundraising
